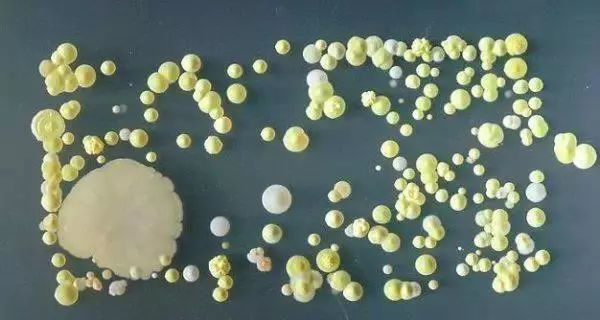

原標題:關(guān)注| 被央視畫面嚇哭,你天天抱著吃飯的東西,比馬桶還臟…
誰是你最親密的TA
不是他?也不是她!
答案竟是它
手機

你白天捧著它
晚上捧著它
沒事的時候摸摸它
有事的時候玩玩它……
然而
它卻比廁所沖水按鈕還臟
不騙你,
央視已經(jīng)曝光了
呃,那畫面“太美”
建議正吃東西的小伙伴先別看
如果你幾乎每時每刻都把手機放在身邊
那你的手機上很有可能堆滿了細菌
下面放的照片告訴你真相——
注意!前方高能,請坐穩(wěn)扶好!
↓↓

一起來看看實驗檢測
↓↓
檢測人員將采集到的包括出租車司機的小屏幕手機、小朋友不停在玩著手機游戲的蘋果手機等,不同的幾部手機提取樣本分別與培養(yǎng)皿進行涂抹接觸。在此之后,所有樣本放置于恒溫恒濕的孵箱之內(nèi)靜待觀察。

經(jīng)過了第一個24小時,大部分的培養(yǎng)皿中都長出了小如針尖,大如小米大小的菌落,但一部經(jīng)常被擦拭的手機培養(yǎng)皿中與之前并無區(qū)別,看似非常干凈。但在第二個24小時過后,之前看似干凈的培養(yǎng)皿中也未能幸免,同樣長出了很多肉眼可見的菌落,而之前針尖大小的菌落變成了米粒大小。
在經(jīng)過了第三個24小時,我們發(fā)現(xiàn)送檢的每一個培養(yǎng)皿中都長出了不同顏色以及大小清晰的菌落,最大的有硬幣大小。

△這是一位經(jīng)常用酒精擦拭手機的出租汽車司機的手機細菌情況。

△這是一位在手機屏幕臟得看不下去的時候會用手擦拭的女士的手機細菌情況。

△這個是一位小朋友父親手機的細菌情況。

△這個是一位稱手機臟得像便后不洗手一樣的大娘的手機細菌情況。
專家表示:“有人做過實驗,測試100個護士手機,有24個存在病原菌。一個密切接觸公共環(huán)境的人,手機存在病原菌污染的可能性就高。手傳給手機,手機又通過打電話,與鼻子、皮膚、耳朵傳給打電話的人。很多病原菌會攜帶7天左右,特殊的還能更長到21天左右?!?/p>
(來源:中國青年報)
(責任編輯 王順利)